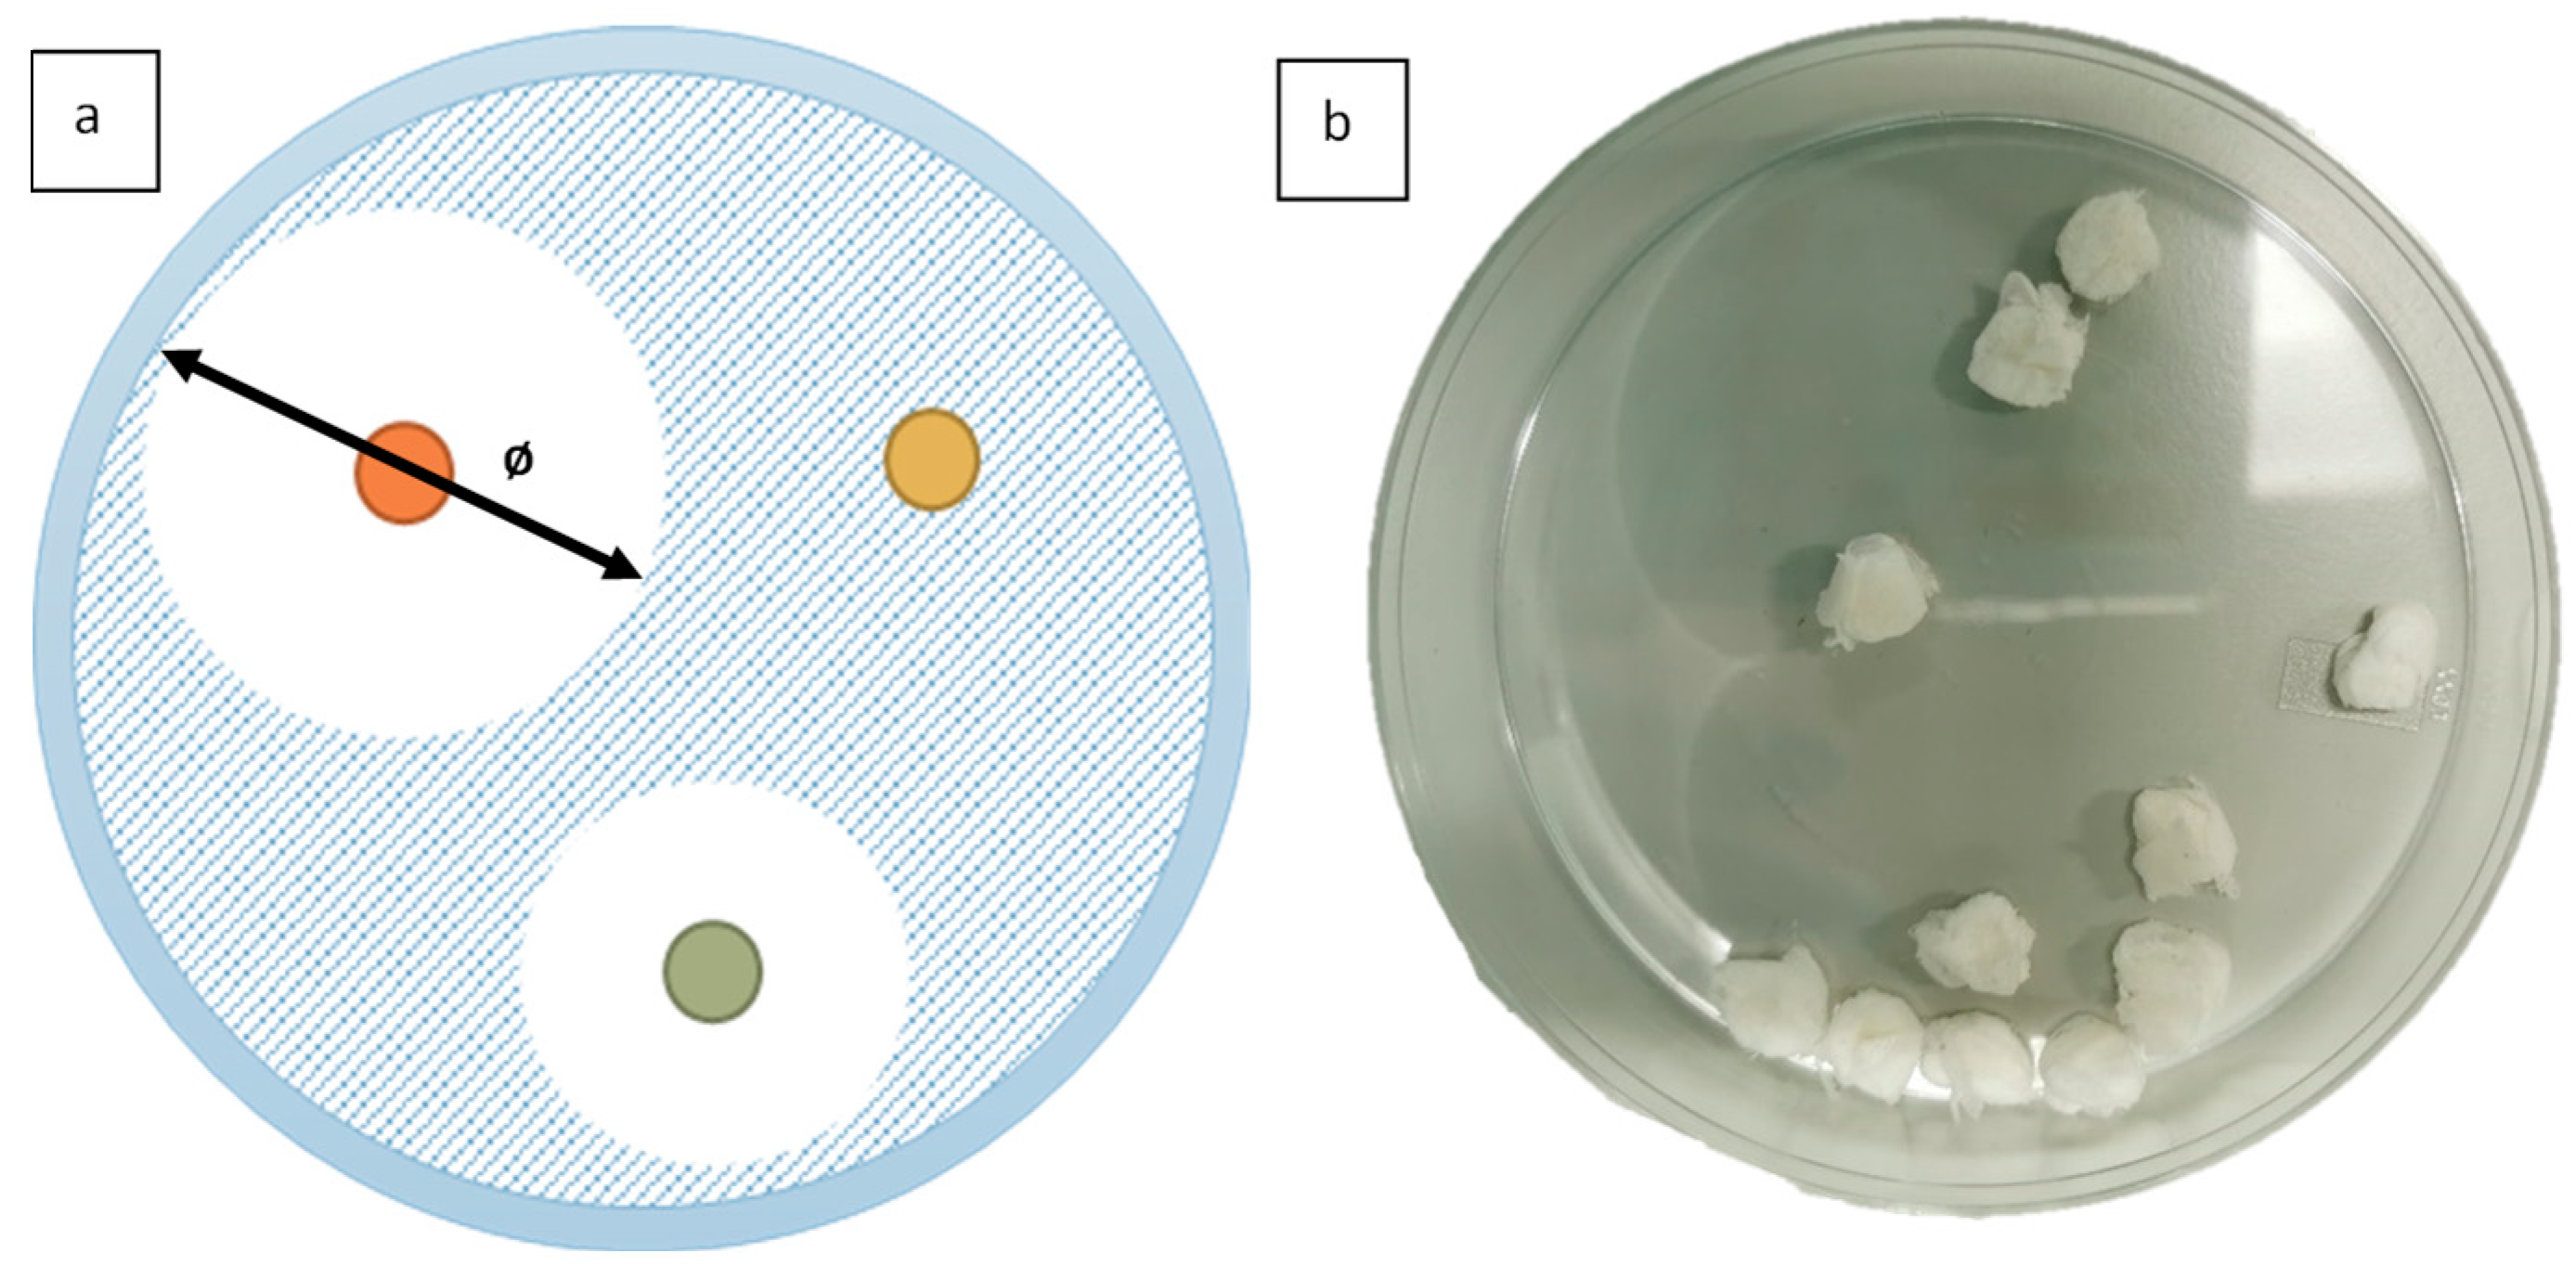
Jfb 13 00136 g003

Antimicrobial Fibrous Bandage-like Scaffolds Using Clove Bud Oil
Abstract
:1. Introduction
2. Materials and Methods
2.1. Fibre Preparation
2.2. Anti-Microbial Testing
3. Results and Discussion
3.1. Fourier-Transform Infrared Spectroscopy
3.2. Antimicrobial Testing
4. Conclusions
Author Contributions
Funding
Institutional Review Board Statement
Informed Consent Statement
Data Availability Statement
Acknowledgments
Conflicts of Interest
References
- Petrovska, B.B. Historical review of medicinal plants’ usage. Pharmacogn. Rev. 2012, 6, 1–5. [Google Scholar] [CrossRef] [PubMed]
- Kelly, A.; Ahmed, J.; Edirisinghe, M. Manufacturing Cyclodextrin Fibers Using Water. Macromol. Mater. Eng. 2022, 307, 2100891. [Google Scholar] [CrossRef]
- Shedoeva, A.; Leavesley, D.; Upton, Z.; Fan, C. Wound Healing and the Use of Medicinal Plants. Evid. Based Complement. Alternat. Med. 2019, 2019, 2684108. [Google Scholar] [CrossRef] [PubMed]
- Yousaf, S.; Hanif, M.A.; Rehman, R.; Azeem, M.W.; Racoti, A. Chapter 32—Indian Pennywort. In Medicinal Plants of South Asia; Hanif, M.A., Nawaz, H., Khan, M.M., Byrne, H.J., Eds.; Elsevier: Amsterdam, The Netherlands, 2020; pp. 423–437. [Google Scholar] [CrossRef]
- Balekar, N.; Katkam, N.G.; Nakpheng, T.; Jehtae, K.; Srichana, T. Evaluation of the wound healing potential of Wedelia trilobata (L.) leaves. J. Ethnopharmacol. 2012, 141, 817–824. [Google Scholar] [CrossRef] [PubMed]
- Conti, P.; Caraffa, A.; Gallenga, C.E.; Ross, R.; Kritas, S.K.; Frydas, I.; Younes, A.; Di Emidio, P.; Ronconi, G.; Pandolfi, F. Powerful anti-inflammatory action of luteolin: Potential increase with IL-38. Biofactors 2021, 47, 165–169. [Google Scholar] [CrossRef] [PubMed]
- Sharma, A.; Khanna, S.; Kaur, G.; Singh, I. Medicinal plants and their components for wound healing applications. Future J. Pharm. Sci. 2021, 7, 53. [Google Scholar] [CrossRef]
- Chaieb, K.; Hajlaoui, H.; Zmantar, T.; Kahla-Nakbi, A.B.; Rouabhia, M.; Mahdouani, K.; Bakhrouf, A. The chemical composition and biological activity of clove essential oil, Eugenia caryophyllata (Syzigium aromaticum L. Myrtaceae): A short review. Phytother. Res. 2007, 21, 501–506. [Google Scholar] [CrossRef]
- Jitender, S.; Anupama, B.; Goel, S.P. Eugenia caryophyllata Thunberg (family Myrtaceae): A review. Int. J. Res. Pharm. Biomed. Sci. 2012, 3, 1469–1475. [Google Scholar]
- Moon, S.-E.; Kim, H.-Y.; Cha, J.-D. Synergistic effect between clove oil and its major compounds and antibiotics against oral bacteria. Arch. Oral Biol. 2011, 56, 907–916. [Google Scholar] [CrossRef]
- Mahulette, A.S.; Hariyadi; Yahya, S.; Wachjar, A. Physico-chemical properties of clove oil from three forest clove accession groups in Maluku. IOP Conf. Ser. Earth Environ. Sci. 2020, 418, 012028. [Google Scholar] [CrossRef]
- El Ghallab, Y.; Al Jahid, A.; Jamal Eddine, J.; Ait Haj Said, A.; Zarayby, L.; Derfoufi, S. Syzygium aromaticum L.: Phytochemical investigation and comparison of the scavenging activity of essential oil, extracts and eugenol. Adv. Tradit. Med. 2020, 20, 153–158. [Google Scholar] [CrossRef]
- Marchese, A.; Barbieri, R.; Coppo, E.; Orhan, I.E.; Daglia, M.; Nabavi, S.F.; Izadi, M.; Abdollahi, M.; Nabavi, S.M.; Ajami, M. Antimicrobial activity of eugenol and essential oils containing eugenol: A mechanistic viewpoint. Crit. Rev. Microbiol. 2017, 43, 668–689. [Google Scholar] [CrossRef]
- Campbell, J.L.; Coyer, F.M.; Mudge, A.M.; Robertson, I.M.; Osborne, S.R. Candida albicans colonisation, continence status and incontinence-associated dermatitis in the acute care setting: A pilot study. Int. Wound J. 2017, 14, 488–495. [Google Scholar] [CrossRef]
- Nobile, C.J.; Johnson, A.D. Candida albicans Biofilms and Human Disease. Annu. Rev. Microbiol. 2015, 69, 71–92. [Google Scholar] [CrossRef]
- Márquez-Rodríguez, A.S.; Nevárez-Baca, S.; Lerma-Hernández, J.C.; Hernández-Ochoa, L.R.; Nevárez-Moorillon, G.V.; Gutiérrez-Méndez, N.; Muñoz-Castellanos, L.N.; Salas, E. In Vitro Antibacterial Activity of Hibiscus sabdariffa L. Phenolic Extract and Its In Situ Application on Shelf-Life of Beef Meat. Foods 2020, 9, 1080. [Google Scholar] [CrossRef]
- Cheng, S.; Clancy, C.J.; Checkley, M.A.; Handfield, M.; Hillman, J.D.; Progulske-Fox, A.; Lewin, A.S.; Fidel, P.L.; Nguyen, M.H. Identification of Candida albicans genes induced during thrush offers insight into pathogenesis. Mol. Microbiol. 2003, 48, 1275–1288. [Google Scholar] [CrossRef]
- Rasko, D.A.; Rosovitz, M.J.; Myers, G.S.A.; Mongodin, E.F.; Fricke, W.F.; Gajer, P.; Crabtree, J.; Sebaihia, M.; Thomson, N.R.; Chaudhuri, R.; et al. The Pangenome Structure of Escherichia coli: Comparative Genomic Analysis of E. coli Commensal and Pathogenic Isolates. J. Bacteriol. 2008, 190, 6881–6893. [Google Scholar] [CrossRef]
- Qadri, F.; Svennerholm, A.-M.; Faruque, A.S.G.; Sack, R.B. Enterotoxigenic Escherichia coli in Developing Countries: Epidemiology, Microbiology, Clinical Features, Treatment, and Prevention. Clin. Microbiol. Rev. 2005, 18, 465–483. [Google Scholar] [CrossRef]
- Fernandez, J.; Hilliard, J.J.; Morrow, B.J.; Melton, J.L.; Flamm, R.K.; Barron, A.M.; Lynch, A.S. Efficacy of a New Fluoroquinolone, JNJ-Q2, in Murine Models of Staphylococcus aureus and Streptococcus pneumoniae Skin, Respiratory, and Systemic Infections. Antimicrob. Agents Chemother. 2011, 55, 5522–5528. [Google Scholar] [CrossRef]
- Sadikot, R.T.; Blackwell, T.S.; Christman, J.W.; Prince, A.S. Pathogen-host interactions in Pseudomonas aeruginosa pneumonia. Am. J. Respir. Crit. Care Med. 2005, 171, 1209–1223. [Google Scholar] [CrossRef] [Green Version]
- Johansson, L.; Norrby-Teglund, A. Immunopathogenesis of streptococcal deep tissue infections. Curr. Top. Microbiol. Immunol. 2013, 368, 173–188. [Google Scholar] [CrossRef] [PubMed]
- Capoor, M.R.; Nair, D.; Deb, M.; Batra, K.; Aggarwal, P. Resistance to erythromycin and rising penicillin MIC in Streptococcus pyogenes in India. Jpn. J. Infect. Dis. 2006, 59, 334–336. [Google Scholar] [PubMed]
- Mosti, G.; Mattaliano, V.; Partsch, H. Influence of different materials in multicomponent bandages on pressure and stiffness of the final bandage. Dermatol. Surg. 2008, 34, 631–639. [Google Scholar] [CrossRef] [PubMed]
- Okur, M.E.; Karantas, I.D.; Şenyiğit, Z.; Üstündağ Okur, N.; Siafaka, P.I. Recent trends on wound management: New therapeutic choices based on polymeric carriers. Asian J. Pharm. Sci. 2020, 15, 661–684. [Google Scholar] [CrossRef]
- Tobudic, S.; Kratzer, C.; Lassnigg, A.; Presterl, E. Antifungal susceptibility of Candida albicans in biofilms. Mycoses 2012, 55, 199–204. [Google Scholar] [CrossRef]
- Wenzel, R.P.; Gennings, C. Bloodstream infections due to Candida species in the intensive care unit: Identifying especially high-risk patients to determine prevention strategies. Clin. Infect. Dis. 2005, 41 (Suppl. S6), S389–S393. [Google Scholar] [CrossRef]
- Pal, S.; Sayana, A.; Joshi, A.; Juyal, D. Staphylococcus aureus: A predominant cause of surgical site infections in a rural healthcare setup of Uttarakhand. J. Family Med. Prim. Care 2019, 8, 3600–3606. [Google Scholar] [CrossRef]
- Hong, X.; Edirisinghe, M.; Mahalingam, S. Beads, beaded-fibres and fibres: Tailoring the morphology of poly(caprolactone) using pressurised gyration. Mater. Sci. Eng. C 2016, 69, 1373–1382. [Google Scholar] [CrossRef]
- Heseltine, P.L.; Hosken, J.; Agboh, C.; Farrar, D.; Homer-Vanniasinkam, S.; Edirisinghe, M. Fiber Formation from Silk Fibroin Using Pressurized Gyration. Macromol. Mater. Eng. 2019, 304, 1800577. [Google Scholar] [CrossRef]
- Ahmed, J.; Gultekinoglu, M.; Bayram, C.; Kart, D.; Ulubayram, K.; Edirisinghe, M. Alleviating the toxicity concerns of antibacterial cinnamon-polycaprolactone biomaterials for healthcare-related biomedical applications. MedComm 2021, 2, 236–246. [Google Scholar] [CrossRef]
- Ahmed, J.; Altun, E.; Aydogdu, M.O.; Gunduz, O.; Kerai, L.; Ren, G.; Edirisinghe, M. Anti-fungal bandages containing cinnamon extract. Int. Wound J. 2019, 16, 730–736. [Google Scholar] [CrossRef]
- Aydogdu, O.M.; Altun, E.; Ahmed, J.; Gunduz, O.; Edirisinghe, M. Fiber forming capability of binary and ternary compositions in the polymer system: Bacterial cellulose–polycaprolactone–polylactic Acid. Polymers 2019, 11, 1148. [Google Scholar] [CrossRef]
- Altun, E.; Aydogdu, M.O.; Togay, S.O.; Sengil, A.Z.; Ekren, N.; Haskoylu, M.E.; Oner, E.T.; Altuncu, N.A.; Ozturk, G.; Crabbe-Mann, M.; et al. Bioinspired Scaffold Induced Regeneration of Neural Tissue. Eur. Polym. J. 2019, 114, 98–108. [Google Scholar] [CrossRef]
- Rong, D.; Chen, P.; Yang, Y.; Li, Q.; Wan, W.; Fang, X.; Zhang, J.; Han, Z.; Tian, J.; Ouyang, J. Fabrication of Gelatin/PCL Electrospun Fiber Mat with Bone Powder and the Study of Its Biocompatibility. J. Funct. Biomater. 2016, 7, 6. [Google Scholar] [CrossRef]
- Domalik-Pyzik, P.; Morawska-Chochół, A. Preliminary Results on Heparin-Modified Double-Layered PCL and PLA-Based Scaffolds for Tissue Engineering of Small Blood Vessels. J. Funct. Biomater. 2022, 13, 11. [Google Scholar] [CrossRef]
- Prakasam, M.; Locs, J.; Salma-Ancane, K.; Loca, D.; Largeteau, A.; Berzina-Cimdina, L. Biodegradable Materials and Metallic Implants—A Review. J. Funct. Biomater. 2017, 8, 44. [Google Scholar] [CrossRef] [PubMed]
- Abdul Khodir, W.K.; Abdul Razak, A.H.; Ng, M.H.; Guarino, V.; Susanti, D. Encapsulation and Characterization of Gentamicin Sulfate in the Collagen Added Electrospun Nanofibers for Skin Regeneration. J. Funct. Biomater. 2018, 9, 36. [Google Scholar] [CrossRef]
- Biggemann, J.; Müller, P.; Köllner, D.; Simon, S.; Hoffmann, P.; Heik, P.; Lee, J.H.; Fey, T. Hierarchical Surface Texturing of Hydroxyapatite Ceramics: Influence on the Adhesive Bonding Strength of Polymeric Polycaprolactone. J. Funct. Biomater. 2020, 11, 73. [Google Scholar] [CrossRef]
- Khatami, M.; Varma, R.S.; Zafarnia, N.; Yaghoobi, H.; Sarani, M.; Kumar, V.G. Applications of green synthesized Ag, ZnO and Ag/ZnO nanoparticles for making clinical antimicrobial wound-healing bandages. Sustain. Chem. Pharm. 2018, 10, 9–15. [Google Scholar] [CrossRef]
- Nešporová, K.; Pavlík, V.; Šafránková, B.; Vágnerová, H.; Odráška, P.; Žídek, O.; Císařová, N.; Skoroplyas, S.; Kubala, L.; Velebný, V. Effects of wound dressings containing silver on skin and immune cells. Sci. Rep. 2020, 10, 15216. [Google Scholar] [CrossRef] [PubMed]
- Heseltine, P.L.; Ahmed, J.; Edirisinghe, M. Developments in pressurized gyration for the mass production of polymeric fibers. Macromol. Mater. Eng. 2018, 303, 1800218. [Google Scholar] [CrossRef]
- Ahmed, J.; Gultekinoglu, M.; Edirisinghe, M. Bacterial cellulose micro-nano fibres for wound healing applications. Biotechnol. Adv. 2020, 41, 107549. [Google Scholar] [CrossRef] [PubMed]
- Illangakoon, E.U.; Mahalingam, S.; Matharu, K.R.; Edirisinghe, M. Evolution of Surface Nanopores in Pressurised Gyrospun Polymeric Microfibers. Polymers 2017, 9, 508. [Google Scholar] [CrossRef] [PubMed]
- Kuppan, P.; Sethuraman, S.; Krishnan, U.M. PCL and PCL-gelatin nanofibers as esophageal tissue scaffolds: Optimization, characterization and cell-matrix interactions. J. Biomed. Nanotechnol. 2013, 9, 1540–1555. [Google Scholar] [CrossRef] [PubMed]
- Liverani, L.; Lacina, J.; Roether, J.A.; Boccardi, E.; Killian, M.S.; Schmuki, P.; Schubert, D.W.; Boccaccini, A.R. Incorporation of bioactive glass nanoparticles in electrospun PCL/chitosan fibers by using benign solvents. Bioact. Mater. 2018, 3, 55–63. [Google Scholar] [CrossRef] [PubMed]
- Mohammed, M.J.; Al-Bayati, F.A. Isolation and identification of antibacterial compounds from Thymus kotschyanus aerial parts and Dianthus caryophyllus flower buds. Phytomedicine 2009, 16, 632–637. [Google Scholar] [CrossRef]
- Hudzicki, J. Kirby-Bauer disk diffusion susceptibility test protocol. Am. Soc. Microbiol. 2009, 15, 55–63. [Google Scholar]
- Kim, E.-H.; Kim, H.-K.; Ahn, Y.-J. Acaricidal Activity of Clove Bud Oil Compounds against Dermatophagoides farinae and Dermatophagoides pteronyssinus (Acari: Pyroglyphidae). J. Agric. Food Chem. 2003, 51, 885–889. [Google Scholar] [CrossRef]
- Devi, K.P.; Nisha, S.A.; Sakthivel, R.; Pandian, S.K. Eugenol (an essential oil of clove) acts as an antibacterial agent against Salmonella typhi by disrupting the cellular membrane. J. Ethnopharmacol. 2010, 130, 107–115. [Google Scholar] [CrossRef]
- Kim, W.-K.; Song, S.-Y.; Oh, W.K.; Kaewsuwan, S.; Tran, T.L.; Kim, W.-S.; Sung, J.-H. Wound-healing effect of ginsenoside Rd from leaves of Panax ginseng via cyclic AMP-dependent protein kinase pathway. Eur. J. Pharmacol. 2013, 702, 285–293. [Google Scholar] [CrossRef]
- Zhang, Y.; Wang, Y.; Zhu, X.; Cao, P.; Wei, S.; Lu, Y. Antibacterial and antibiofilm activities of eugenol from essential oil of Syzygium aromaticum (L.) Merr. & L. M. Perry (clove) leaf against periodontal pathogen Porphyromonas gingivalis. Microb. Pathog. 2017, 113, 396–402. [Google Scholar] [CrossRef]

Publisher’s Note: MDPI stays neutral with regard to jurisdictional claims in published maps and institutional affiliations. |
© 2022 by the authors. Licensee MDPI, Basel, Switzerland. This article is an open access article distributed under the terms and conditions of the Creative Commons Attribution (CC BY) license (https://creativecommons.org/licenses/by/4.0/).
Share and Cite
von Thadden, C.; Altun, E.; Aydogdu, M.; Edirisinghe, M.; Ahmed, J. Antimicrobial Fibrous Bandage-like Scaffolds Using Clove Bud Oil. J. Funct. Biomater. 2022, 13, 136. https://doi.org/10.3390/jfb13030136
von Thadden C, Altun E, Aydogdu M, Edirisinghe M, Ahmed J. Antimicrobial Fibrous Bandage-like Scaffolds Using Clove Bud Oil. Journal of Functional Biomaterials. 2022; 13(3):136. https://doi.org/10.3390/jfb13030136
Chicago/Turabian Stylevon Thadden, Carlota, Esra Altun, Mehmet Aydogdu, Mohan Edirisinghe, and Jubair Ahmed. 2022. "Antimicrobial Fibrous Bandage-like Scaffolds Using Clove Bud Oil" Journal of Functional Biomaterials 13, no. 3: 136. https://doi.org/10.3390/jfb13030136
APA Stylevon Thadden, C., Altun, E., Aydogdu, M., Edirisinghe, M., & Ahmed, J. (2022). Antimicrobial Fibrous Bandage-like Scaffolds Using Clove Bud Oil. Journal of Functional Biomaterials, 13(3), 136. https://doi.org/10.3390/jfb13030136

